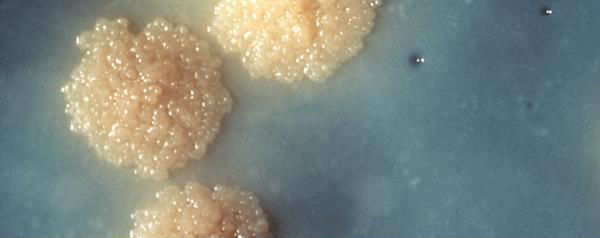

Een lange lijst met veel soorten van resistente tuberculose, dat is wat vier teams van onderzoekers hebben gemaakt. Met deze catalogus kunnen artsen adequaat handelen als ze te maken krijgen met een resistente vorm van tuberculose.
Het is nooit fijn om de tering te krijgen. Als je onverhoopt toch slachtoffer wordt van tuberculose (tbc), dan wordt er een antibioticakuur tegenaan gegooid en ben je na een tijdje weer genezen. Er is alleen een groeiend probleem: tbc wordt alsmaar resistenter tegen onze antibiotica. In 2010 waren er minstens 650.000 gevallen van tuberculose waarbij de meest gebruikelijke antibiotica niet werkten. In 2012 werden in India de eerste gevallen gemeld van complete resistentie. Kortom: een vorm van tuberculose die we niet kunnen genezen met de huidige antibiotica.
Een ander probleem waar wetenschappers tegenaan lopen is dat de manier waarop tuberculose resistent wordt nog niet helemaal bekend is. In Nature Genetics publiceerden vier teams van wetenschappers over Mycobacterium tuberculosis met als conclusie: het ligt nóg complexer dan we eigenlijk dachten. Onze kennis van de genetische basis van tuberculose is namelijk nog niet compleet genoeg om de manier waarop tuberculose resistent wordt te begrijpen.
Het goede nieuws
Dezelfde vier teams met onderzoekers hebben een groot aantal soorten tbc gesequencet en onderzocht. Het resultaat is een kaart waarop de verschillende soorten tuberculose staan, inclusief de vorm van resistentie.
Er zijn uiteenlopende tactieken die een muterende tuberculose kan toepassen om antibiotica te omzeilen. Er bestaan bijvoorbeeld mutaties waarbij de celwand van structuur of doorlaatbaarheid veranderd. Andere mutaties hebben invloed op moleculaire pompen die de antibiotica wegjagen. Weer andere mutaties vergroten de snelheid van muteren, waardoor gunstige mutaties sneller worden opgepakt. Met het in kaart brengen van al deze mutatiesoorten voorkom je dat artsen een antibioticum toedienen die niet werkt bij een specifiek geval van tbc.
Ander goed nieuws is dat er al een tijdje een wereldwijde afname is in het aantal tbc-patiënten. Alleen in China is het gevecht tegen resistente tuberculose nog hevig. Daar is bijna 6 procent van de nieuwe tbc-gevallen resistent tegen meerdere soorten antibiotica, en 8 procent van de gevallen zeer uitgebreid resistent. Daar is dus voor de toekomst nog de grootste slag te slaan.
Bronnen: Nature Genetics (1), Nature Genetics (2), Nature Genetics (3), Nature News
Beeld: Dr. George Kubica/CDC